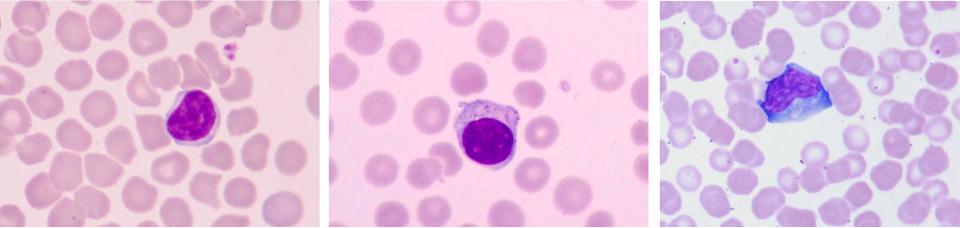

Материал: клинический+анализ+крови+3

Метахромазия
В поле зрения три базофила, зернистость которых приобрела цвет, отличный от цвета красителя – краснофиолетовый вместо синего.
Ортохромные клетки окрашиваются в цвет красителя. При метахромазии окрашивающийся субстрат приобретает цвет отличный от цвета красителя. Это исползуется для отличия базофильной зернистости от другой в сомнительных случаях. Она окрашивается толуидиновым синим в красно-фиолетовый цвет. Всё остальное – в бледно-синий.

Лимфатическая ткань
Mucosa-associated lymphoid tissue
Entero-associated lymphoid tissue
Bronch-associated lymphoid tissue

Схема лимфоидного фолликула

Схема заключительного этапа
В-лимфопоэза
Плазмоциты
Иммунобласт Про- плазмоцит
В-лимфоцит
Переходная
Антигенный клетка стимул
В2- В-клетка лимфоцит памяти
Агранулоциты не содержат специфической зернистости
Типичный малый |
Большой гранулярный лимфоцит |
Лифоиммуноцит |
лимфоцит |
|
|
Большие гранулярные лимфоциты относятся к Т-клеткам. Они содержат в цитоплазме неспецифическую азурофильную зернистость. Это единственные лимфоциты, которые можно уверенно отнести к Т-линии без специального исследования с мКА.
Лимфоиммуноциты образуются из Т-клеток вследствие бласттранформации под воздействием вируса Эпштейна-Барр, (Epstein-Barr virus, EBV), иногда при других вирусных инфекциях.